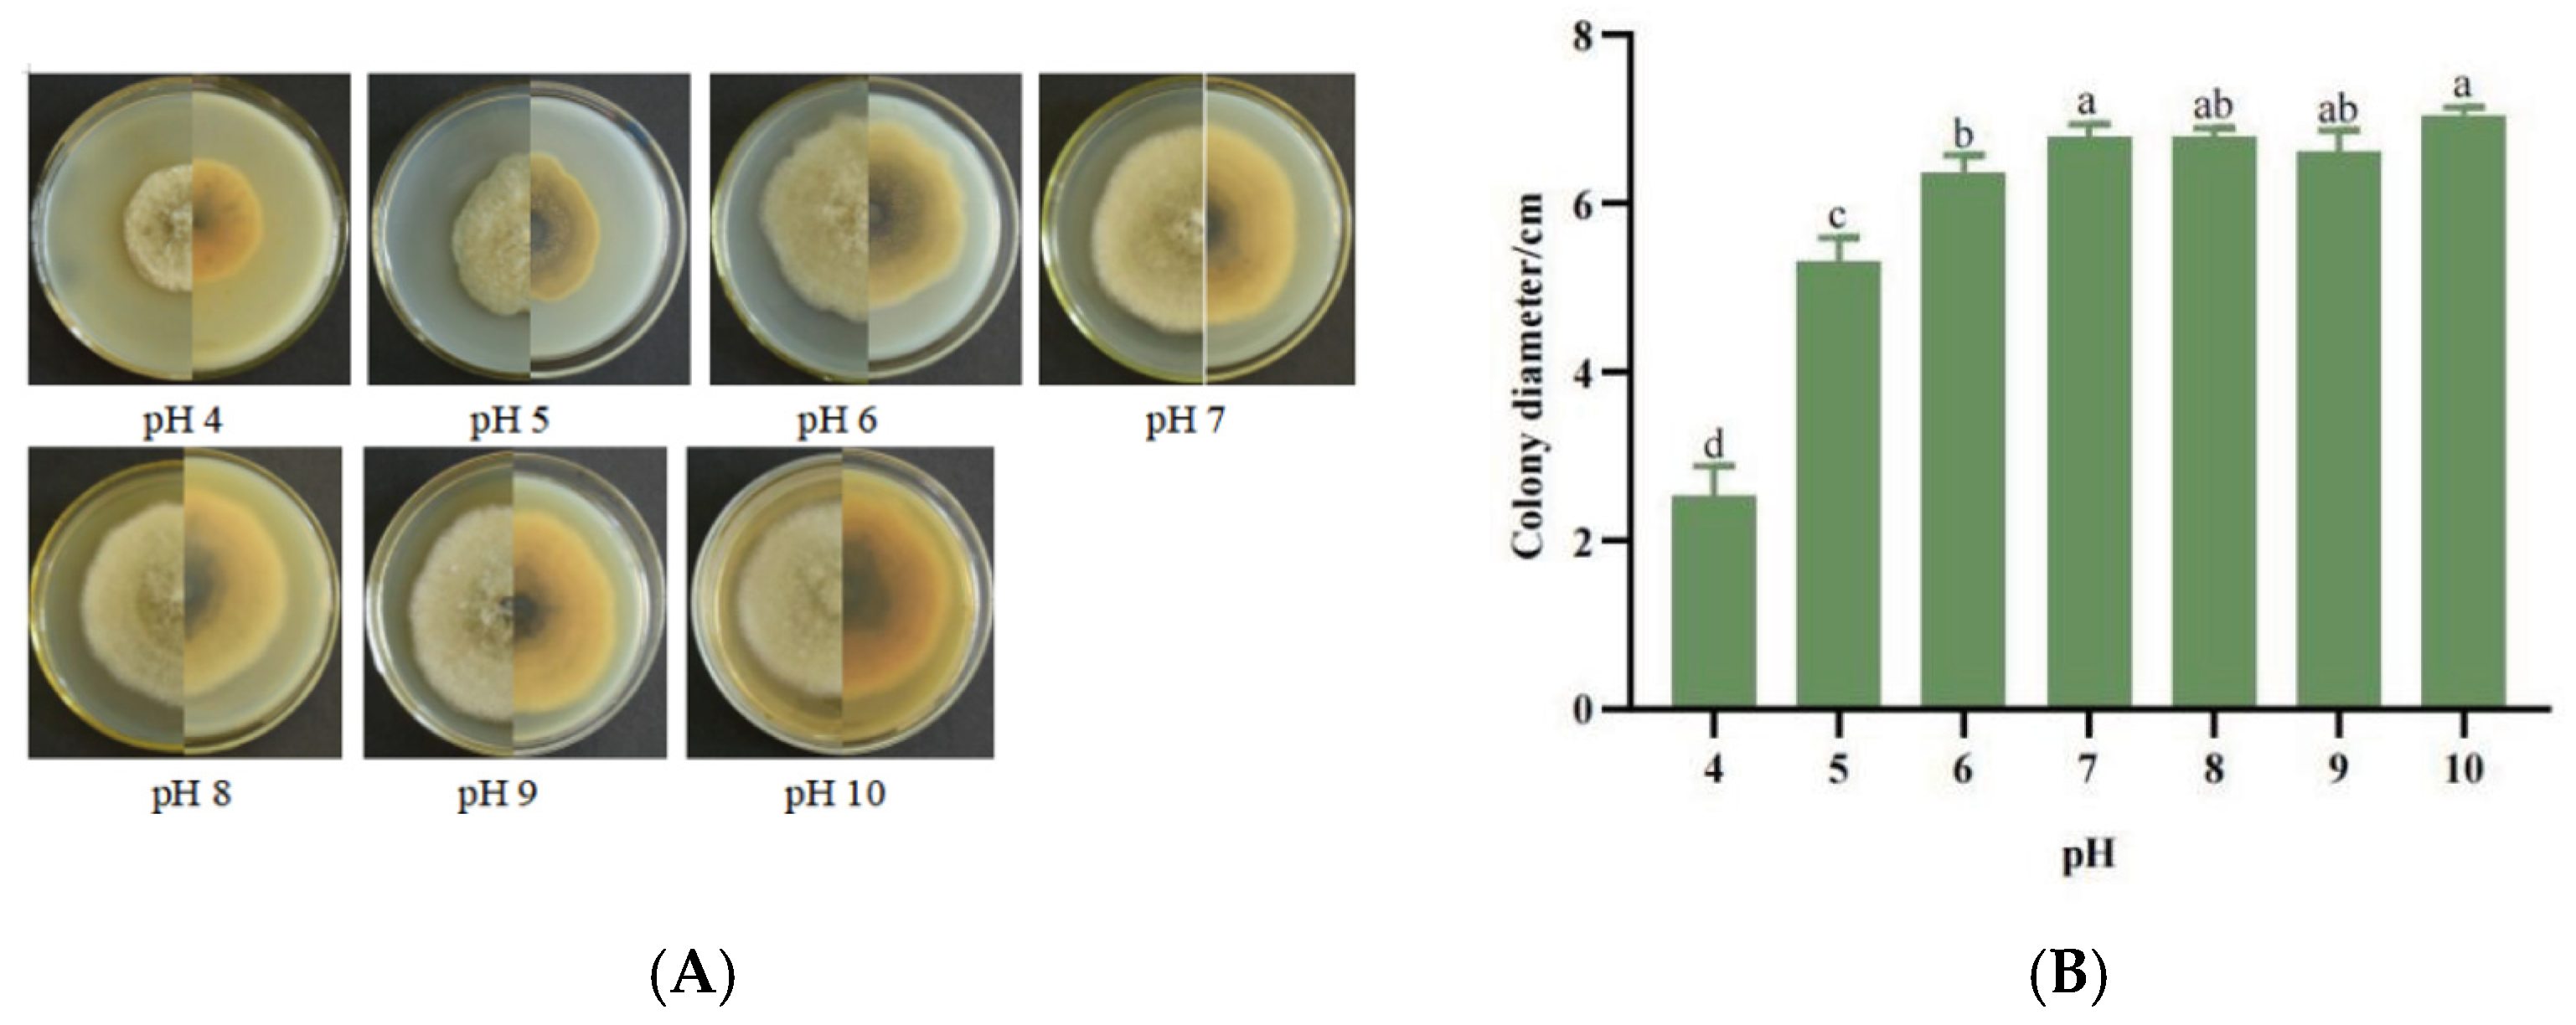
Jof 11 00872 g005 Jof 11 00872 g005

Correction: Feng et al. Identification and Biological Characteristics of Alternaria gossypina as a Promising Biocontrol Agent for the Control of Mikania micrantha. J. Fungi 2024, 10, 691
Reference
- Feng, L.; Hu, L.; Bo, J.; Ji, M.; Ze, S.; Ding, Y.; Yang, B.; Zhao, N. Identification and Biological Characteristics of Alternaria gossypina as a Promising Biocontrol Agent for the Control of Mikania micrantha. J. Fungi 2024, 10, 691. [Google Scholar] [CrossRef] [PubMed]
Disclaimer/Publisher’s Note: The statements, opinions and data contained in all publications are solely those of the individual author(s) and contributor(s) and not of MDPI and/or the editor(s). MDPI and/or the editor(s) disclaim responsibility for any injury to people or property resulting from any ideas, methods, instructions or products referred to in the content. |
© 2025 by the authors. Licensee MDPI, Basel, Switzerland. This article is an open access article distributed under the terms and conditions of the Creative Commons Attribution (CC BY) license (https://creativecommons.org/licenses/by/4.0/).
Share and Cite
Feng, L.; Hu, L.; Bo, J.; Ji, M.; Ze, S.; Ding, Y.; Yang, B.; Zhao, N. Correction: Feng et al. Identification and Biological Characteristics of Alternaria gossypina as a Promising Biocontrol Agent for the Control of Mikania micrantha. J. Fungi 2024, 10, 691. J. Fungi 2025, 11, 872. https://doi.org/10.3390/jof11120872
Feng L, Hu L, Bo J, Ji M, Ze S, Ding Y, Yang B, Zhao N. Correction: Feng et al. Identification and Biological Characteristics of Alternaria gossypina as a Promising Biocontrol Agent for the Control of Mikania micrantha. J. Fungi 2024, 10, 691. Journal of Fungi. 2025; 11(12):872. https://doi.org/10.3390/jof11120872
Chicago/Turabian StyleFeng, Lichen, Lianrong Hu, Jingyi Bo, Mei Ji, Sangzi Ze, Yan’e Ding, Bin Yang, and Ning Zhao. 2025. "Correction: Feng et al. Identification and Biological Characteristics of Alternaria gossypina as a Promising Biocontrol Agent for the Control of Mikania micrantha. J. Fungi 2024, 10, 691" Journal of Fungi 11, no. 12: 872. https://doi.org/10.3390/jof11120872
APA StyleFeng, L., Hu, L., Bo, J., Ji, M., Ze, S., Ding, Y., Yang, B., & Zhao, N. (2025). Correction: Feng et al. Identification and Biological Characteristics of Alternaria gossypina as a Promising Biocontrol Agent for the Control of Mikania micrantha. J. Fungi 2024, 10, 691. Journal of Fungi, 11(12), 872. https://doi.org/10.3390/jof11120872

